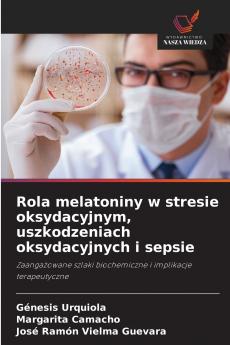
Rola melatoniny w stresie oksydacyjnym uszkodzeniach oksydacyjnych i sepsie

Paperback
₹5302
₹6831
22.38% OFF
(All inclusive*)
Delivery Options
Please enter pincode to check delivery time.
*COD & Shipping Charges may apply on certain items.
Review final details at checkout.
Looking to place a bulk order? SUBMIT DETAILS
About The Book
Description
Author(s)
Aby opisać ogólne koncepcje wolnych rodników stresu oksydacyjnego uszkodzeń oksydacyjnych i dowodów uzyskanych w modelach in vivo i in vitro na temat potencjalnego zastosowania melatoniny w różnych infekcjach bakteryjnych (Gram-dodatnich i Gram-ujemnych) oraz rozwoju sepsy przeprowadziliśmy jakościowy przegląd systematyczny z kryteriami walidacji informacji korzystając z siedmiu wyszukiwarek metawyszukiwarek i baz danych: Google Scholar WebMD Trip Medscape PubMed NICE i Scielo w wyniku czego wyszukano 380.792 dokumentów przy użyciu kombinacji słów kluczowych w języku angielskim i hiszpańskim oraz operatorów logicznych: AND OR lub NOT. Złożona patofizjologia różnych infekcji bakteryjnych i posocznicy pozwoliła nam wywnioskować że istnieje wzajemne powiązanie między stresem oksydacyjnym uszkodzeniami oksydacyjnymi aktywnością przeciwutleniaczy wrodzoną odpornością i mitochondriami. Analiza dowodów pozwoliła nam wskazać że melatonina działa przeciwzapalnie poprzez szlaki czynnika jądrowego kappa beta i inflammasomu NLRP3; oprócz jej właściwości jako zmiatacza wolnych rodników.
Delivery Options
Please enter pincode to check delivery time.
*COD & Shipping Charges may apply on certain items.
Review final details at checkout.
Details
ISBN 13
9786208687656
Publication Date
-27-02-2025
Pages
-68
Weight
-106 grams
Dimensions
-152x229x4.14 mm